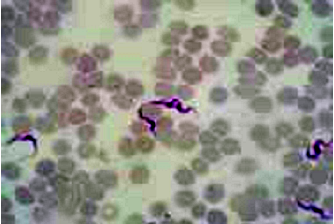
tryp 1

โรคทริพพาโนโซโมซิส (Trypanosomosis)
สาเหตุและการติดต่อ
เกิดจากเชื้อโปรโตซัว ชนิดที่พบในกระแสโลหิตของโคนมในประเทศไทย คือ ทริพพาโนโซมา อีแวนซาย (Trypanosoma evansi) เชื้อนี้จะพบอยู่นอกเม็ดเลือดแดง มีแมลงนี้ไปเกาะและดูดเลือดโค ก็จะปล่อยเชื้อเข้าสู่กระแสโลหิต
อาการ
โดยธรรมชาติโคนมไม่ค่อยแสดงอาการให้เห็นเด่นชัดนอกจากซีดและผอม แต่ในรายที่เป็นรุนแรงจะมีไข้ ตาอักเสบหรือขุ่น ขาแข็ง หลังแข็ง คอบิด โลหิตจาง อาจตายอย่างเฉียบพลันได้ ในโคท้องจะแท้งลูกในช่วงตั้งแต่ 4 เดือนขึ้นไป หรืออาจคลอดก่อนกำหนด น้ำหนักลูกแรกคลอดต่ำ รกค้างในโครีดนมน้ำนมลด ส่วนในโคท้องว่างจะไม่แสดงอาการเป็นสัดและอาจมีอาการทางประสาท เช่น เดิน ตื่นตระหนก กระโดด ดุร้าย ซึม เป็นอัมพาต
การตรวจวินิจฉัย
1. ตรวจเลือดสด เจาะเลือดใส่สารกันเลือดแข็งตัว หยดเลือดบนสไลด์ ปิดด้วยคอพเวอร์กล๊าส ตรวจหาเชื้อด้วยกล้องจุลทรรศน์
2. นำเลือดโคที่สงสัยเป็นโรค ทำฟิล์มเลือดบางๆ บนสไลด์ย้อมด้วยสียิมซ่า ตรวจดูเชื้อด้วยกล้องจุลทรรศน์
3. นำเลือดโคมาฉีดเข้าช่องท้องหนูไมซ์ หลังจากนั้น 3-5 วัน ตัดหางหนู หยดเลือดบนสไลด์ ปิดด้วยคอพเวอร์กล๊าส ตรวจดูเชื้อด้วยกล้องจุลทรรศน์
การรักษา
มียาหลายชนิดที่ใช้รักษาแล้วได้ผลดี และที่มีจำหน่ายในประเทศ คือ เบรานิล (Berenil®) ใชขนาด 3 มิลลิกรัม/น้ำหนักตัวสัตว์ 1 กิโลกรัม ฉีดเข้ากล้ามเนื้อ
การควบคุมและป้องกัน
1. กำจัดแมลงนำโรคโดยการใช้ยาฆ่าแมลง แต่มีข้อเสียคือยาราคาแพงและต้องทำในพื้นที่กว้าง
2. ฉีดยาซาโมริน (Samorin®) ให้โคเพื่อป้องกันก่อนถึงฤดูฝนและเมื่อหมดฤดูฝน ในขนาด 0.5-1.0 มิลลิกรัม/น้ำหนักตัวสัตว์ 1 กิโลกรัม สามารถป้องกันโรคได้นาน 3-4 เดือน
ที่มา
ทัศนีย์ ชมภูจันทร์, มนัสนันนท์ ประสิทธิรัตน์ และมนยา เอกทัตร์ (บรรณาธิการ). 2539. คู่มือการดูแลสุขภาพโคนม" สถาบันสุขภาพสัตว์แห่งชาติ. ฟันนี่พับบลิชิ่ง.
ทัศนีย์ ชมภูจันทร์, สุรีย์ ธรรมศาสตร์, ปนันท์ ธนเจริญวัชร, จิรา คงครอง และเอกรินทร์ วัฒนพลาชัยกูร (บรรณาธิการ). 2539. คู่มือมาตรฐานการชันสูตรโรคสัตว์. สถาบันสุขภาพสัตว์แห่งชาติ.โรงพิมพ์ชุมนุมสหกรณ์การเกษตรแห่งประเทศไทย.









กระทรวงเกษตรและสหกรณ์
กรมปศุสัตว์